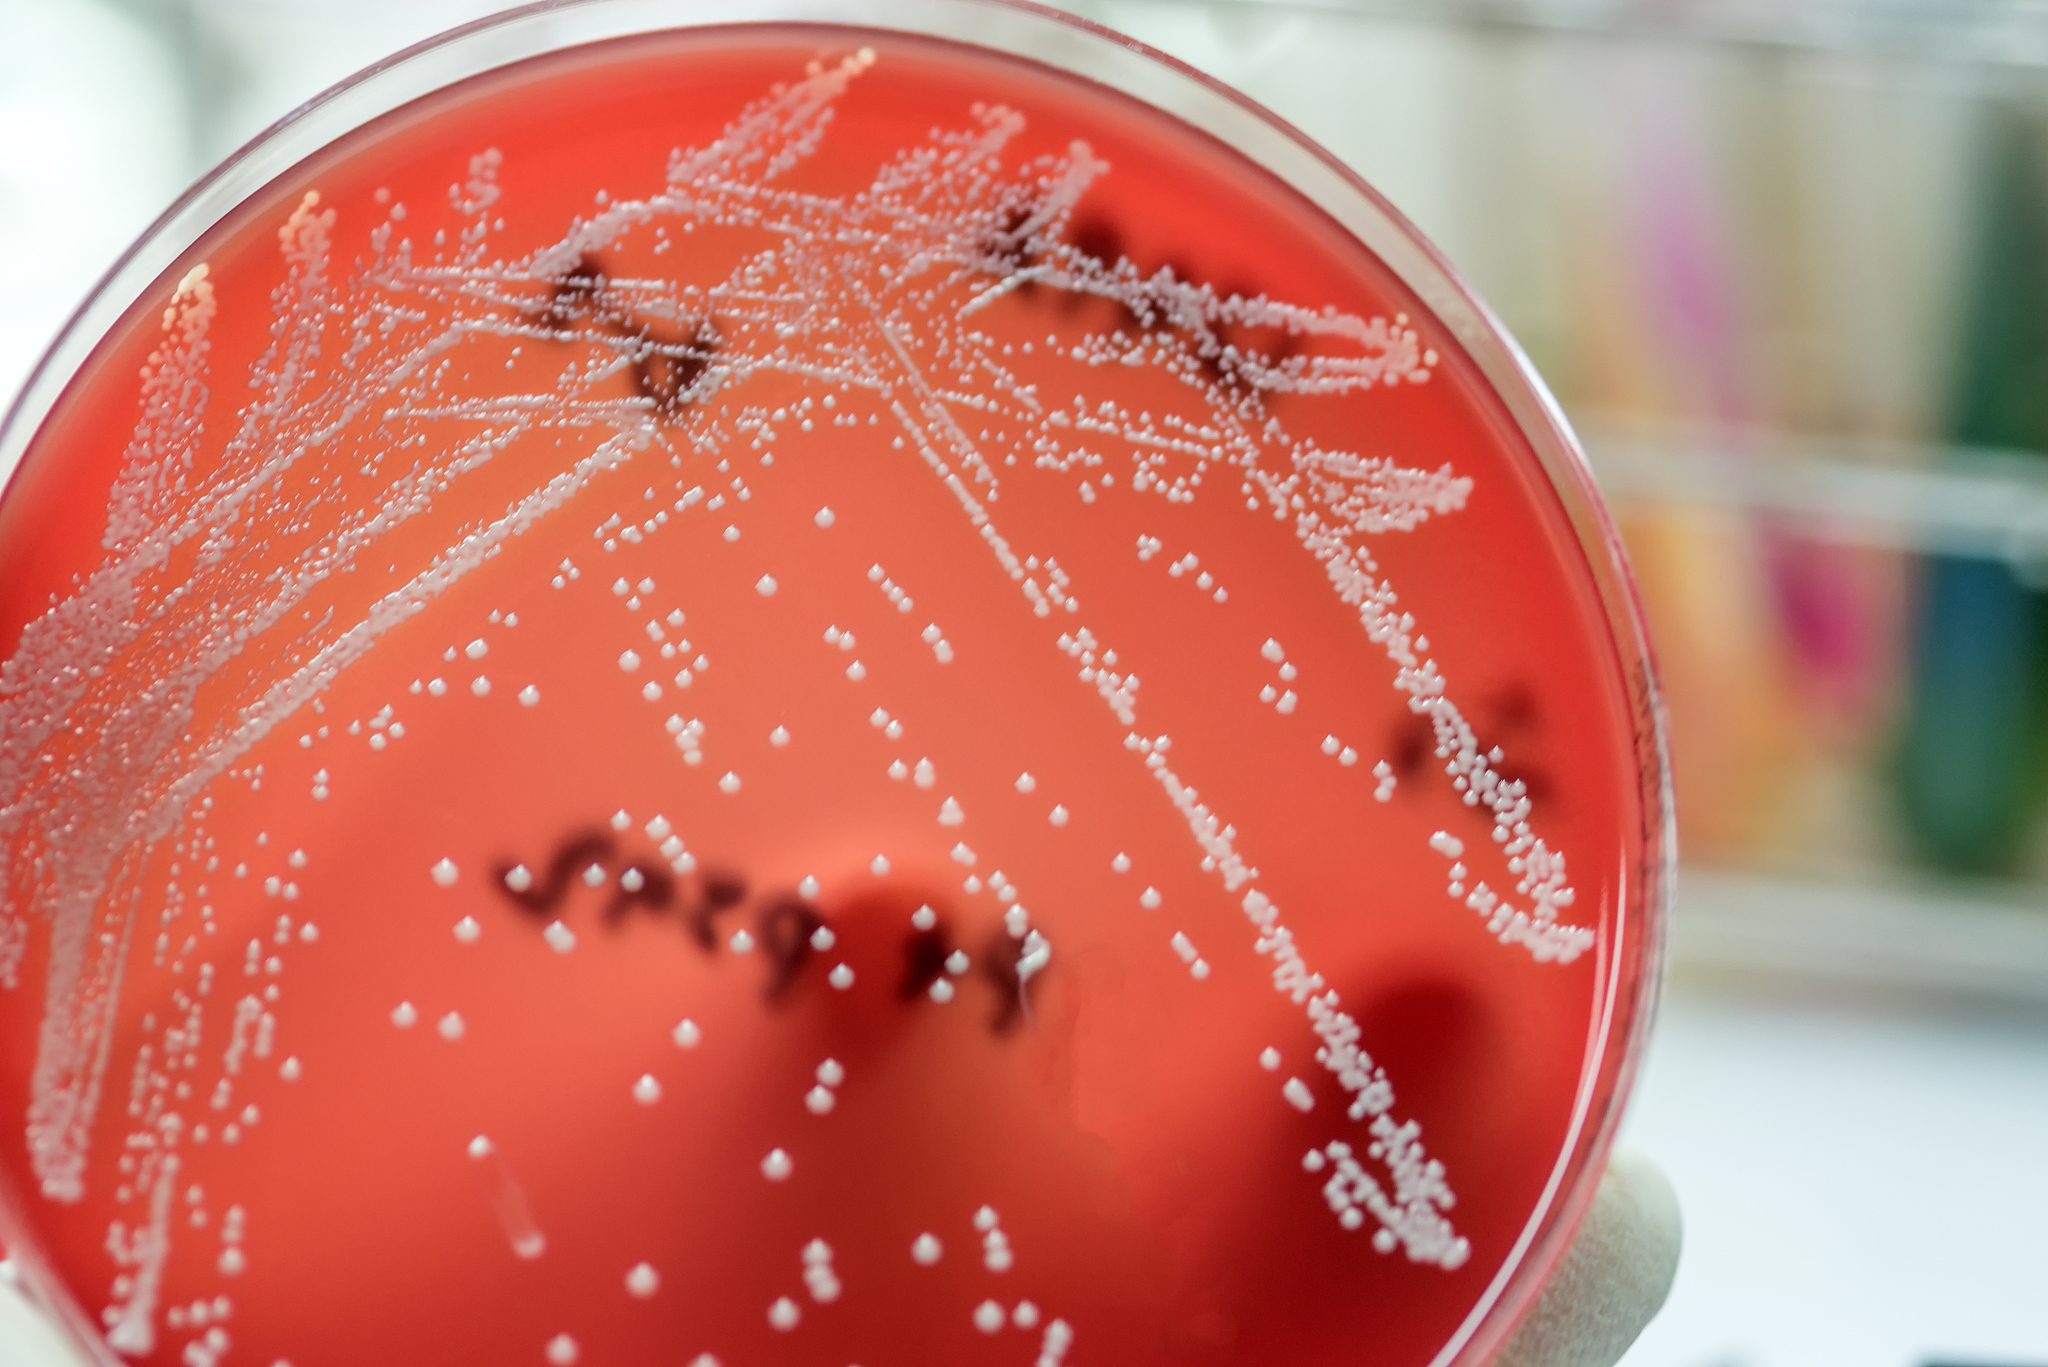
真菌-细菌共培养技术在医疗方面的应用请举几个详细的例子详细到真菌细菌名称都要写出来

真菌-细菌共培养技术在医疗方面的应用请举几个详细的例子详细到真菌细菌名称都要写出来
-
深部真菌感染的诊断:深部真菌感染是由真菌引起的一种严重的感染疾病,诊断需要对患者的体液或组织进行检测。常用的方法是将样本同时接种在真菌和细菌的培养基上,例如Sabouraud培养基和MacConkey培养基。真菌在Sabouraud培养基上生长良好,而细菌在MacConkey培养基上生长良好,通过观察生长情况,可以确定样本中是否存在真菌和细菌感染。
-
喜马拉雅酸快速检测:喜马拉雅酸是一种由某些真菌产生的有毒代谢产物,可以导致霉菌病。利用真菌-细菌共培养技术,可以将病人样本接种在含有喜马拉雅酸的培养基上,同时加入一种敏感的细菌,例如红色荧光蛋白杆菌。如果喜马拉雅酸存在,会抑制红色荧光蛋白杆菌的生长,从而观察到细菌生长受到抑制的现象,可以快速检测出喜马拉雅酸的存在。
-
菌群平衡检测:人体内的菌群平衡对健康非常重要,真菌-细菌共培养技术可以用于检测人体内的菌群平衡。例如将人体样本接种在含有真菌和细菌的培养基上,观察不同菌群的生长情况,可以了解人体内真菌和细菌的比例,从而判断菌群是否平衡。如果真菌过多或细菌过少,可能会导致疾病的发生。
原文地址: https://www.cveoy.top/t/topic/fa1y 著作权归作者所有。请勿转载和采集!